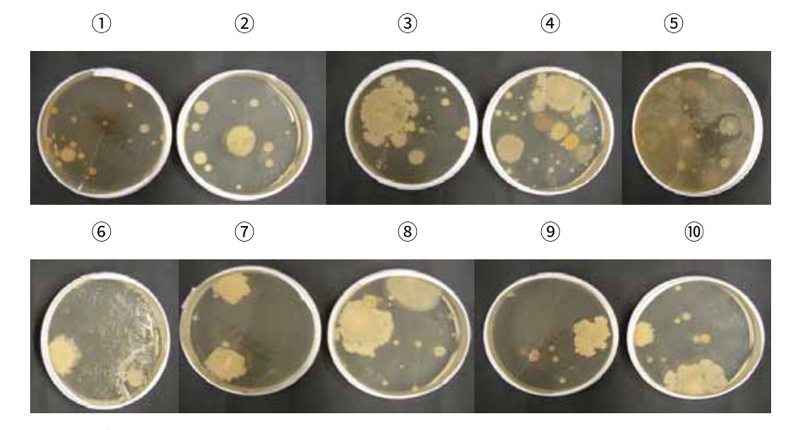
歯科クリニック 対照試験区
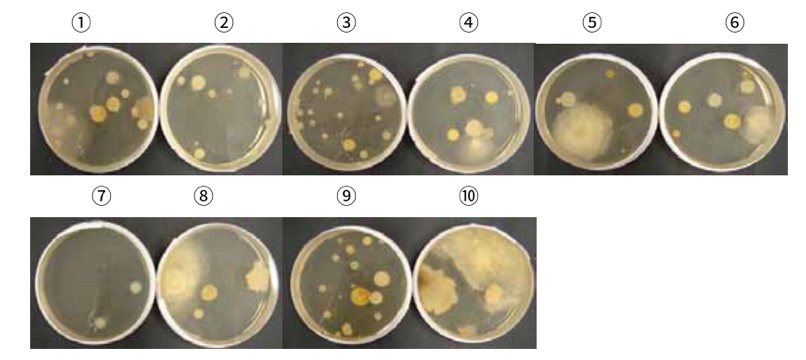
○○○○温泉病院 対照試験区
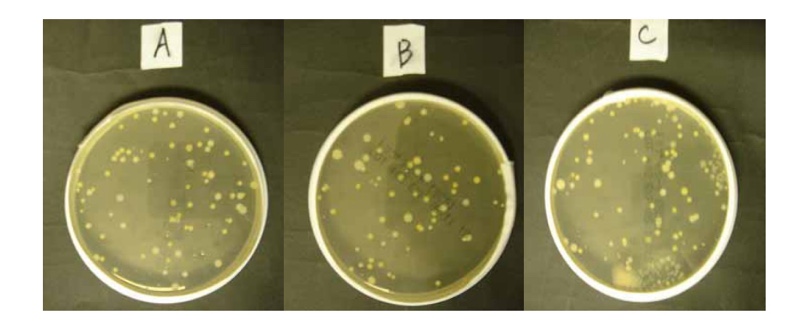
社内 対照試験区

落下菌抑制効果の検証結果

毎日の空間を「清潔に保つ」ために
消臭抗菌アロマディフューザーSEAROMA(シーロマ)は、消臭と同時に、空間における菌やカビの増殖を抑えることを目指した製品です。
医療機関やオフィスに寒天培地を設置し、シーロマ放出の前後で自然落下する菌の数を測定したところ、シーロマによって空間中の菌が減っていることが確認されました。
このページでは、シーロマの落下菌試験の結果をご紹介します。
また、第三者機関による抗菌力試験でも、菌やカビの増殖が抑制されることが確認されました。詳細は別ページでご紹介しています。
SEAROMA(シーロマ)抗菌力試験結果
落下菌抑制効果の検証
試験の目的
空気中の浮遊菌は落下して環境を汚染し、院内感染や衛生リスクに直結する。シーロマを使用することで、自然に落下した菌がどの程度抑制されるかを検証した。
試験方法
シーロマを使用しない状態で寒天培地を複数箇所に設置し、5~6時間経過後に蓋を閉め、培地上の菌数を対照群とした。
次に、シーロマを43~336時間連続で稼働させ、その後も断続的に稼働させた状態で、同じ場所に寒天培地を再設置し、培地上の菌数を処理群とした。
その後、寒天培地をインキュベータ(設定37℃)で48時間培養し、それぞれで得られた落下菌数を比較した。
試験結果:各施設での落下菌の変化
1.○○○歯科クリニック(待合室・診察室)
寒天培地は下図の①~⑩に設置し、シーロマは★の位置に設置した。
シーロマ稼働後、10箇所中9箇所(①~⑧、⑩)で落下菌数の減少が確認された。
一方で減少がみられなかった⑨については、シーロマ設置位置からの距離があったことに加え、付近の加湿器の影響があった可能性が示唆される。

(対照試験区)シーロマなし
(処理試験区)シーロマあり

2.○○○○温泉病院(1F病棟)
寒天培地は下図の①~⑩に設置し、シーロマは★の位置に設置した。
シーロマ稼働後、10箇所全てで落下菌数の減少が確認された。
試験協力病院 医師のコメント:
今回の結果で、全ての寒天培地において、緑膿菌・MRSA等落下菌の減少および感染の起因になるホコリ等の除去を確認することができた。シーロマを継続的に稼働させることが、院内感染等の二次感染予防に非常に有効であると考えられる。

(対照試験区)シーロマなし
(処理試験区)シーロマあり

3.医療法人○○○病院(病室411号)
寒天培地は下図の①~③に設置し、シーロマは★の位置に設置した。
シーロマ稼働後、3箇所全てで落下菌数の減少が確認された。
シーロマから比較的遠い場所②の培地の菌数も減少していたことから、シーロマを稼働させることでより安全な病室空間の実現が可能になることを確認した。

(対照試験区)シーロマなし

(処理試験区)シーロマあり

4.株式会社◯◯◯(事務所)
寒天培地は下図のⒶ~Ⓒに設置し、シーロマは★の位置に設置した。
シーロマ稼働後、3箇所全てで落下菌数の減少が確認された。
オフィス環境においても落下菌の抑制効果があることを確認した。

(対照試験区)シーロマなし
(処理試験区)シーロマあり

まとめ
医療機関およびオフィスでの落下菌試験において、シーロマを継続的に稼働させることで空間中の落下菌数が抑制されることが確認できました。
日々の業務で手が回りにくい環境でも、シーロマを稼働させておけば目に見えない菌の増殖を抑え、手間をかけずに清潔な環境を維持できます。
こんな場所で活躍します
シーロマは、スイッチを入れるだけで「消臭・抗菌・芳香」が叶う、シンプルな設計が特徴です。家庭から医療現場まで幅広いシーンでご利用いただけます。

来客が多い場所に
「お客さまに、清潔で心地よい空間だと思ってほしい」
クリニックの待合室やホテルのロビー、オフィスのエントランスなど、人が集まる場所で菌の数を抑え、安心感のある空間づくりをサポートします。

働く空間を快適に
「社員が気持ちよく働ける職場にしたい」
オフィスや会議室、休憩スペースなど、人の出入りが多い場所でも継続的にケア。空間全体に清潔な空気が広がり、快適な職場環境づくりにつながります。
